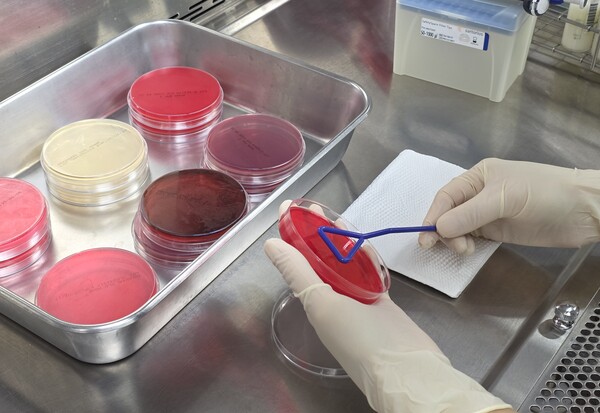

전남도, 폭염 속 낙농가 사양·위생관리 강화 당부
페이지 정보

본문
전라남도동물위생시험소는 폭염으로 젖소의 고온 스트레스가 심화되면서 면역력 저하와 함께 원유 생산량 및 품질 저하가 우려된다며, 낙농가에 철저한 관리와 위생 강화를 당부했습니다.
이에 따라 축사에는 그늘막과 송풍기, 환기시설을 갖추고, 시원한 물과 영양 보충제를 공급해 사료 섭취량을 유지해야 합니다.
전남도는 체세포수 3등급 이상 농가를 대상으로 유방염 방제사업을 함께 추진하고 있습니다.